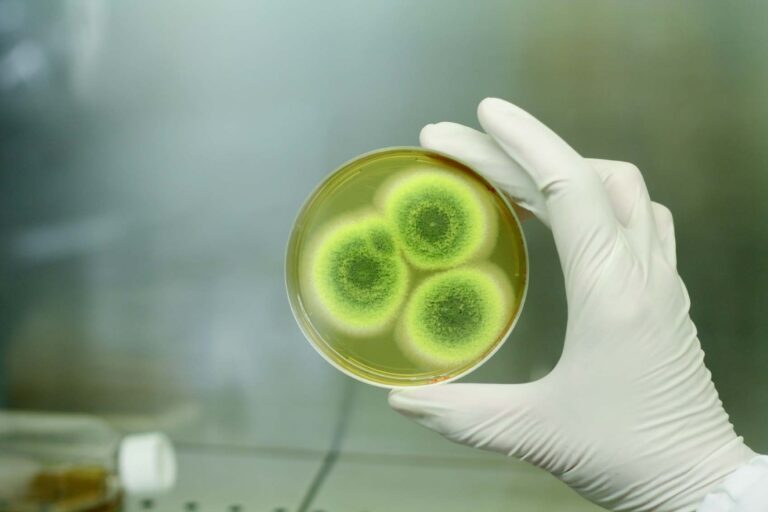
Mould & Mildew

Industry News
Section Title
3 Oct 2017 Date 22 Sep 2017 Time 6:00 pm – Venue Red Apron Wine Cellar &...
27 Sep 2017 Date 17 Sep 2017 Time 9:00 am – 12:00 noon Venue BNH Hospital...
The Mid-Autumn Festival – A Time to Be Together With Family and Friends 26 Sep 2017 If you are new...
19 Sep 2017 Date 12 Sep 2017 – 13 Sep 2017 Time 9:00 am – 5:00 pm Venue ...
The Real Cost of Expatriate Assignment Failure 5 Sep 2017 Rob Chipman, President of FIDI, and CEO of Asian Tiger in...
Beyond the Honeymoon: The 4 Stages of Expat Life 18 Aug 2017 Rob Chipman explains the typical four phases that...
Mould & Mildew grow very easily, here are preventive solutions! While moving can leave one’s possession pretty beaten up, there...
The wild tiger is one of the most symbolic creatures in terms of majesty and strength. Even at that, it...
27 Jul 2017 Date 1 Jul 2017 Time – Venue Waitanyuan On Saturday, July 1, 2017...